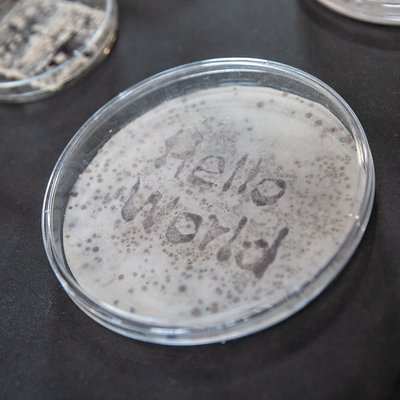
OPEN CALL: Prémio STARTS 2021

Novos alunos do Mestrado em Media Arts são recebidos hoje, no gnration
Esta tarde, damos as boas-vindas aos alunos que, no ano letivo de 2025/2026, frequentam pela primeira vez o Mestrado em Media Arts pela Universidade do Minho.
- #ensino



Esta tarde, damos as boas-vindas aos alunos que, no ano letivo de 2025/2026, frequentam pela primeira vez o Mestrado em Media Arts pela Universidade do Minho.

Hoje, dia 15 de setembro, assinala-se o Dia Internacional da Democracia, data celebrada pela ONU desde 2007.

Entre 5 e 14 de setembro, o gnration, em Braga, recebe a habitual exposição Pós-Laboratórios de Verão, que este ano é composta por quatro obras que exploram os contornos que delimitam a fronteira entre o humanos e o mais-que-humano.

Diretamente das cidades de Braga e de Guimarães (respetivamente), os projetos ODE – Orquestra de Dispositivos Eletrónicos e Outra Voz juntam-se pela primeira vez em palco para celebrar a improvisação ...

Desenvolvido numa parceria entre a Ars Electronica e a Radio Ö1, no âmbito do projeto European Digital Deal, o segundo episódio do podcast Art Is Not A Thing junta a dupla de artistas ...

A The Wrong Biennale apresenta a 7ª edição e promove uma open call onde convida artistas a explorar as potencialidades da Inteligência Artificial e integrar a exposição "Moons, Castles, Trees“, ...

Depois do sucesso da primeira temporada do The Digital Deal Podcast, a Ars Electronica junta-se à Radio Ö1 e apresenta a segunda temporada da série. Adotando um novo nome, Art Is Not ...

O programa de residências artísticas ANIMAIS, promovido pelo grupo artístico CADA, está de volta para uma 3º edição dedicada aos novos media. Destinada a artistas emergentes, re-emergentes e recém licenciados, residentes ...

Em 2025, o gnration volta a receber as propostas artísticas de um conjunto de artistas emergentes através da eMMA – Exposição do Mestrado em Media Arts da Universidade do Minho. De ...

Após o primeiro Urban Living Lab, organizado em Braga no passado mês de fevereiro, a Braga Media Arts participou no segundo encontro do projeto UrbCitizenPower – Empower citizens for agency ...

Nos últimos meses do ano, são mais de 20 as atividades que poderemos encontrar na agenda do Circuito – Serviço Educativo Braga Media Arts. A pensar nos mais diversos públicos - ...

Já é conhecido o cartaz completo para a 15ª edição do festival Semibreve, que acontece em Braga de 23 a 26 de outubro. Nazar, NAH, Grand River, Yara Asmar, Rafael Toral, Marta De Pascalis ...

O Município de Braga anunciou a proposta de requalificação do Cineteatro São Geraldo e do edifício Pé Alado, intervenção que dará forma a um novo Media Arts Centre, espaço que servirá o ...

Depois de 12 anos sob a alçada de Dominique Roland, a equpa de coordenação da sub-rede de Media Arts sofreu uma mudança, passando a ser liderada por Joana Miranda (Braga, PT), Laura Odegaard (Austin, EUA) e Daniela Burkhardt (Karlsruhe, GER).

É a imagem que fala. Eu movo-me com ela e ela move-se comigo, é uma questão de respiração. É prosaico, não é poético. É a imagem que fala e eu ...

Promovido pela Câmara Municipal de Lisboa, o programa “Residência Artística em Artes Tecnológicas e Multimédia” regressa para a 3ª edição com uma open call para artistas, aberta até dia 30 de junho.

Destinado a artistas internacionais que explorem a arte e a criatividade digital, o Bright Festival (Leipzig, Alemanha) promove, até 15 de junho, a open call “New Media Art Projects 2025" com ...

“Making Kin Cells, Software, Synthetic Selves” (em português "Criar Kin Cells, software e seres sintéticos") é o título da discussão que reúne as opiniões de Charlotte Jarvis, Zoran Srdić Janežič e ...

A ser acolhida pela Universidade do Minho (Braga) em novembro deste ano, a 12ª Conferência Internacional de Artes Digitais e Interativas - ARTECH 2025 promove uma open call que convoca ...

Imersa em sessões de criação desde março deste ano, a ODE – Orquestra de Dispositivos Eletrónicos do Circuito sobe ao palco, pela primeira vez este ano, a 7 de junho, ...

O festival de projeções audiovisuais Genius Loci Weimar, na Alemanha, procura artistas internacionais e projetos de video mapping e arquitetura media para integrar a edição de 2025, a decorrer entre 5 e 7 de setembro.

Até 13 de junho, artistas de todas as áreas podem concorrer à open call "S+T+ARTS Aqua Motion", uma iniciativa promovida pelo Programa Europeu S+T+ARTS que oferece residências artísticas de 12 meses, desenvolvidas em Viana do Castelo, Esposende e Lisboa.

Entre 23 e 26 de outubro, a cidade criativa da UNESCO para as Media Arts volta a dar palco ao festival de música eletrónica e arte digital, Semibreve. Actress & ...

O programa de apoio à criação artística – promovido pelo gnration (Braga), CIAJG – Centro Internacional das Artes José de Guimarães (Guimarães) e Solar – Galeria de Arte Cinemática (Vila do ...

AI Cultural Sabotage é a nova extenção online do gnration, que conta com curadoria do editor-fundador da Neural, Alessandro Ludovico. Criado para explorar os meandros da Inteligência Artificial (IA), este ciclo tem estreia marcada ...

O programa Slash está a promover uma nova ronda do projeto Slash Transition e procura 5 novos artistas sonoros provenientes da Áustria, França, Geórgia, Portugal e Tunísia para participar num programa ...

No décimo primeiro episódio do Digital Deal Podcast dá voz à memória e coloca frente a frente as perspetivas da investigadora Yulia Sion, do investigador e artista visual Nuno Correia e do professor Michael Banissy.

Entre maio e agosto, Veneza será palco da nova edição da Borders Art Fair, uma exposição que reúne centenas de artistas internacionais de diversas frentes artísticas. Até 02 de maio, o grupo ...

A mostra fotográfica Encontros da Imagem regressa este ano e promove duas open calls para prémios até 3000€ na área visual.

Até 24 de junho, o festival de música eletrónica e arte digital Semibreve promove uma open call para o Edigma Semibreve Award 2025, uma distinção que destaca trabalhos na área das artes mídia.

Promovido pela Braga 25 – Capital Portuguesa da Cultura, o programa de cinema expandido, CINEX, está de volta com um novo cineconcerto onde a sétima arte e a música se entrelaçam. ...

“A Discovery Guide for Recovery” - um projeto dirigido pela organização cultural Sineglossa e cofinanciado pelo programa Europa Criativa - procura seis artistas interessados em embarcar numa residência artística de duas semanas na ...

A celebrar o seu quinto ano de existência, o Mestrado em Media Arts, promovido pela Universidade do Minho, foi renovado para o novo ano letivo 2025/2026 com 25 novas vagas e candidaturas abertas até ao dia 21 de abril.

Intitulado "Virtualmente real: Escrever espaços transmedia", o décimo episódio do The Digital Deal Podcast traz-nos uma reflexão sobre os espaços que todos os dias habitamos, sejam estes físicos ou digitais. Moderada ...

No dia 11 de abril, o gnration volta a ser palco do Braga International Video Dance Festival, um evento que cruza vídeo e dança, premiando trabalhos interdisciplinares inovadores que desconstroem os tradicionais moldes performativos.

Quais os segredos da produção alimentar das coisas que todos os dias chegam à nossa mesa? Estrelado pelas artistas Špela Petrič e Penelope Cain, e a investigadora Carolien Lubberhuizen, o nono ...

Em abril, o ciclo de formações BMA lab, promovido pelo Circuito – Serviço Educativo Braga Media Arts, convida Hélder da Rocha Pereira para uma masterclass imersiva que cruza cinema, animação 3D e Realidade Virtual.

Depois de passarem pelo ciclo BMA lab do Circuito, no ano passado, a dupla Mobile Radio regressa a território bracarense para orientar um novo workshop de arte radiofónica, promovido pelo Circuito, ...

Os caminhos do cinema e da música cruzam-se e reescrevem-se no CINEX, o novo programa de cinema expandido promovido pela Braga 25 – Capital Portuguesa da Cultura. A 15 de março, ...

Em 2025, o CIAJG – Centro Internacional das Artes José de Guimarães (Guimarães), o gnration (Braga) e a Solar – Galeria de Arte Cinemática (Vila do Conde) anunciam a 11ª edição dos Laboratórios de Verão com a ...

Onassis AiR é um programa internacional de residências e investigação artística promovido pela Fundação Onassis, sediada em Atenas (Grécia). Até 7 de março, artistas, curadores e criadores de todas as áreas ...

Já se encontra aberta a open call para integrar a Rede de Cidades Criativas da UNESCO (UCCN). Até 3 de março, cidades dos países-membro da UNESCO podem candidatar-se à rede ...

Até 28 de fevereiro, a APCA Madeira – Agência de Promoção da Cultura Atlântica promove uma open call destinada a artistas dos arquipélagos da Madeira e dos Açores. Intitulada “Atlânticos - Media Arte”, ...

O Festival Internacional Constellations de Metz (França) está a promover uma open call para artistas, coletivos e agentes culturais que tenham o video mapping como área de interesse. A convocatória desafia ...

A oitava ronda de conversas do Digital Deal Podcast traz à superfície a relação entre a representação, a narração e o design computacional, acompanhando as perspetivas e experiências da dupla dmstfctn e do artista Lawrence Lek.

O Passaporte do Circuito é a nova aposta lançada pelo Serviço Educativo da Braga Media Arts para promover momentos em família. Dirigido aos mais novos (e não só) este passaporte ...

Ícone e lenda-viva da música com quase meio século de carreira, Kim Gordon apresenta pela primeira vez em Portugal uma exposição de retrospectiva do último decénio dos seus trabalhos. "Object of Projection" ...

A Faz Cultura – Empresa Municipal de Cultura de Braga criou o CORDÃO – Coro de Doentes e Amigos Oncológicos, um projeto comunitário composto por pessoas diagnosticadas com cancro, em ...

O LABoral – Centro de Arte e Criação Industrial de Gijón (Espanha) é casa da mais recente exposição do European Digital Deal. “Máquinas digitais” é o título da exibição que preenche o ...

De 29 jan a 1 fev, Braga torna-se palco da música africana, europeia e americana durante a primeira edição do festival Square – Mapping the Atlantic.

A obra "BLUR", desenvolvida pelo artista português Jorge Ramos, a artista sul-coreana Anna Kim e o artista francês Julien Gaillac, foi selecionada para integrar o programa do Performing Media Festival, ...

A Ars Electronica e a Comissão Europeia anunciaram uma open call para a nova edição dos prémios S+T+ARTS, uma iniciativa anual que premeia os projetos mais inovadores na interseção entre ...

O maior e mais antigo concurso de media arts do mundo, Prix Ars Electronica, está de volta e já se encontram abertas as candidaturas aos prémios deste ano.

O festival Sónar +D, em Barcelona (ES), promove uma open call para artistas, criadores, coletivos, estúdios ou start-ups que queiram integrar a nova edição da Project Area, um espaço de exposição interativo inserido no Sónar by Day.

Em 2025, ano em que Braga é Capital Portuguesa da Cultura, a ODE - Orquestra de Dispositivos Eletrónicos celebra a criação musical e convoca novos membros para se juntarem à sua 7ª edição.

Em 2025, Braga torna-se o epicentro cultural do país e assume o título de Capital Portuguesa da Cultura. Maria João Pires, Tiago Rodrigues, Mariza, a dupla Meg Stuart e Francisco ...

Situada na Alemanha, a cidade de Potsdam - Cidade Criativa da UNESCO para o Cinema - lançou uma open call que desafia cineastas provenientes das Cidades Criativas da UNESCO nos domínios do ...

O Circuito - Serviço Educativo Braga Media Arts entra em 2025 de agenda renovada e propõe atividades para toda a família. Entre janeiro e julho, será possível descobrir e explorar temas como ...

Em 2025, o músico e compositor bracarense junta-se à australiana Liza Lim no programa de residências artísticas da Casa da Música do Porto.

Entre outubro de 2024 e janeiro de 2025, o gnration (Braga) acolhe a exposição “Tempo e Tempo”, desenvolvida pelo artista brasileiro Luiz Zanotello em colaboração com Ricardo Vieira. Em parceria ...

O que acontece quando o nosso comportamento social é constantemente monitorizado? No sétimo episódio do “Digital Deal Podcast”, Ana-Maria Carabelea reúne-se com a artista Noemi Iglesias Barrios e com a curadora ...

A cidade designada como Capital Italiana da Cultura em 2024 lançou a primeira edição do Prémio Biosfera. Esta distinção oferece a criativos, artistas, designers e músicos a oportunidade de interagir ...

O coração de Braga volta a encher-se de Media Arts, música eletrónica e arte digital durante a nona edição do #OCUPA, nos dias 06 e 07 de dezembro, no gnration.

Em 2025, o Braga International Video Dance Festival (BIVDF) propõe uma nova incursa pela criação artística em formato vídeo-dança. Já estão abertas as inscrições para a 9ª edição, que acontece ...

O Clube de Inverno do Circuito - Serviço Educativo Braga Media Arts está de volta para mais uma edição onde a música e a imagem em movimento se unem em ...

Depois de passar por Braga durante a Conferência Anual das Cidades Criativas da UNESCO, Mikhail Karikis foi este fim de semana reconhecido com o Paul Hamlyn Foundation Award, uma das maiores distinções artísticas da atualidade.

A Capital Europeia da Cultura 2026 – Oulu 2026 – está a promover uma open call internacional que convida artistas visuais a integrar a nova área artística ARToulu.

A cidade de Braga foi distinguida como uma das cidades mais inovadoras da Europa em 2024. Apoiada pelo European Innovation Council, a 10ª edição dos European Capital of Innovation Awards ...

Até 15 de novembro, a ISEA International convida pessoas ou instituições das áreas da arte, ciência e tecnologia a participar na open call do 30º Simpósio Internacional de Arte Eletrónica ...
![Open Call: Exposição “[Entre Paredes] - no fim de um lugar”](/media/filer_public_thumbnails/filer_public/a3/65/a365b83b-daeb-40f2-8eac-198dbd89b22c/314998675_2699299646870946_5336538381205729993_tb.jpg__400x400_q85_crop_subsampling-2_upscale.jpg)
Até dia 15 de novembro, a Casa das Artes Bissaya Barreto, em Coimbra, propõe uma reflexão acerca daquilo que permanece ou se perde nos limites de um lugar e promove ...

A artista, designer 3D e investigadora polaca, Martyna Marciniak, e o teórico e professor finlandês, Jussi Parikka, juntam-se a Ana-Maria Carabelea no sexto episódio do The Digital Deal Podcast para ...

No mesmo dia em que sobem ao palco do gnration com “Contre Jour”, a dupla formada pelo guitarrista dos Sonic Youth e a artista multimédia homenageia o trabalho de Lourdes Castro numa masterclass apresentada em Braga, a 30 de novembro, promovida pelo Circuito.

De 24 a 27 de outubro, a cidade criativa da UNESCO para as Media Arts torna-se o epicentro da música eletrónica e da arte digital na 14ª. edição do festival ...

No dia 22 de outubro, a EMAP - Plataforma Europeia de Media Arts apresenta o workshop online “Authorship in AI-Generated Art”. Considerando a rápida transformação tecnológica, a sessão propõe uma ...

“Dança de Materiais Inertes” é uma série de instalações e espetáculos da autoria de Marta Cerqueira e Simão Costa. Depois de apresentar a terceira peça desta coleção, #3Movediço, inserida na ...

No dia 9 de novembro, a Braga Media Arts e o Institut Français cruzam a inteligência artificial e a composição artística numa conversa que junta os olhares de Matthias Puech, Morgan Morcel e Ana Carvalho.

Entre outubro e dezembro, o Circuito - Serviço Educativo Braga Media Arts apresenta três novas propostas para o ciclo de formação BMA lab. Orientadas por grandes nomes do universo artístico ...

No dia 12 de outubro, o gnration recebe Rosemary Lee para uma sessão de apresentação da sua mais recente publicação Algorithm, Image, Art, um livro onde a artista e investigadora ...

De 23 a 27 de abril de 2025, a cidade de Osnabrück, na Alemanha, recebe a 38ª edição do EMAF - European Media Art Festival. Antes de fechar o programa desta nova ...

Nos dias 3 e 4 de outubro, o Theatro Circo cruza a arte e a tecnologia na primeira sessão do Frente e Verso. Partindo de narrativas e vocabulários do panorama ...

Até 31 de outubro, a Braga 25 procura cinco propostas artísticas para serem desenvolvidas num shopping do centro de Braga, com o objetivo de dar vida a espaços esquecidos e aproximar a cultura da comunidade.

Até dia 6 de outubro, pequenas e médias empresas do setor cultural e criativo poderão candidatar-se ao primeiro Programa de Aceleração da EIT Culture & Creativity e integrar uma formação intensiva de oito semanas.

Criado em 2015 pelo gnration, o programa Laboratórios de Verão tem vindo a potenciar a criação artística local, apoiando centenas de artistas na disseminação dos seus projetos. Este ano, a ...

Anualmente, o Festival ZERO1 junta mais de vinte artistas e profissionais do setor cultural num encontro que explora a relação entre a arte e a cultura digitais. A caminho da ...

Depois de três anos de trabalho em conjunto com parceiros e jovens de vários países, a Braga Media Arts e o Circuito – Serviço Educativo BMA finalizaram, em julho, o ...

Desenvolvido pelo projeto European Digital Deal e moderado, como habitualmente, por Ana-Maria Carabelea, o quinto episódio do The Digital Deal Podcast junta Meredith Whittaker e Calin Segal numa conversa sobre ...

São mais de 25 as atividades que compõem a nova agenda do Circuito – Serviço Educativo Braga Media Arts. Entre setembro e dezembro, o Circuito promove um programa dedicado à ...

Cinco peças de artistas emergentes europeus configuram a segunda exposição coletiva da série EMAP Perspective, patente no gnration até 16 de agosto.

A Braga 25 e a Braga Voluntária uniram esforços e estão a promover uma open call para pessoas que queiram participar ativamente no plano de ação da Capital Portuguesa da Cultura em 2025. A open call termina a 15 de agosto.

O verão ainda não terminou, mas o Circuito – Serviço Educativo Braga Media Arts já tem um conjunto de propostas para todos os gostos e idades. Dança, música, programação, cinema, ...

Centrada na criação de projetos em novos media, a convocatória ANIMAIS convida artistas emergente e re-emergentes, residentes em Portugal, para participarem numa residência artística no Alentejo, a acontecer no final ...

No dia 25 de julho, a cidade de Barcelos torna-se o epicentro dos jogos na primeira Gamedev Meet Barcelos, um evento criado por alunos e professores do IPCA- Instituto Politécnico do Cávado e Ave.

A Braga 25 e a Lovers & Lollypops estão à procura de artistas e bandas de toda a costa atlântica para participarem na open call Square, uma iniciativa que pretende ...

De 18 a 27 de julho, o gnration recebe a terceira edição da eMMA – Exposição do Mestrado em Media Arts da Universidade do Minho. A exposição coletiva reúne obras ...

No processo da distinção de Braga como Capital Portuguesa da Cultura em 2025, a Braga 25 apresenta a open call Todo-o-Terreno. Com candidaturas abertas até dia 12 de setembro, esta ...

A Academia do Desejar, promovida pela Braga 25, vai juntar membros da comunidade a agentes culturais, educativos e ambientais de Braga para pensar o contexto social da cidade através de um conjunto de Rodas do Conhecimento.

A Universidade do Minho volta a apostar na formação em Media Arts e renova o Mestrado em Media Arts com 25 vagas para o ano letivo de 2024/2025. Depois de uma primeira fase de candidaturas (em abril), a 2ª fase abre este mês, entre os dias 04 e 15.

Entre os dias 1 e 5 de julho, Braga recebe a XVI Conferência Anual da Rede das Cidades Criativas da UNESCO, um evento que trará à cidade cerca de 350 delegações de mais de 100 países.

No quarto episódio do Digital Deal Podcast, Ana-Maria Carabelea senta-se à conversa com a Professora Judy Wajcman e a artista visual e multimédia Silvia Binda, duas figuras separadas pela difereça geracional, mas unidas ...

Desde o início deste ano, o Digital Deal Podcast tem convidado artistas, especialistas de Inteligência Artificial e críticos e teóricos culturais para debater a forma como as novas tecnologias moldam as democracias e ...

O programa de apoio à criação artística, Laboratórios de Verão, regressa em 2024 para a 10ª edição com uma open call aberta até 7 de abril e dirigida a artistas ...

Já são conhecidas as datas para a segunda edição da Bienal de Arte e Tecnologia – INDEX. A iniciativa, promovida pela Braga Media Arts, arranca a 9 e estende-se até ...

Já está disponível o segundo episódio do “Digital Deal Podcast”. Entitulado "Truth Makers (Produtores da verdade)" este episóio cruza as visões de Kasia Chmielinski, Ndapewa Onyothi e Angie Abdilla num debate acerca da forma como o ...

O consórcio de instituições culturais europeias que integram o projeto European Digital Deal anunciou, esta quinta-feira (29 fev), os nomes dos 12 projetos selecionados para o programa de residências artísticas de 2024.

O projeto temperART juntou-se ao Município Feirense para promover duas open calls internacionais, centradas nas áreas das media arts e da gastronomia, até 8 de março.

O Festival Internacional de Vídeo-Dança de Braga (BIVDF) está de regresso para a sua 8.ª edição com open call para submissão de projetos aberta até 29 de fevereiro.

Entre 26 de janeiro e 27 de abril, o gnration, em Braga, acolhe as cinco obras que integram a primeira exposição colaborativa da Plataforma Europeia de Media Art – EMAP.

Conhecido na indústria musical como Dada Garbeck, Rui Souza junta-se ao Circuito para guiar os instrumentos eletrónicos da nova edição da ODE.

No dia 27 de janeiro, o gnration recebe uma formação para professores assente em questões urbanas e ambientais. Promovida pelo Circuito - Serviço Educativo Braga Media Arts, a sessão utilizará como ...

A ODE - Orquestra de Dispositivos Eletrónicos regressa à programação do Circuito e procura novos participantes para se juntarem ao artista Rui Souza na 6ª edição do projeto.

Nos dias 18 (escolas), 19 e 20 (público geral) de janeiro, o Circuito – Serviço Educativo Braga Media Arts apresenta o espetáculo BERTIE, uma experiência de realidade virtual em rede, ...

O programa de residências artísticas do EMAP – Plataforma Europeia de Media Arts – renova-se para mais uma edição e já são conhecidos os nomes dos 16 artistas selecionados.

A música eletrónica e arte digital vão voltar a invadir a cidade de Braga durante a oitava edição do OCUPA, nos dias 15 e 16 de dezembro.

O projeto European Digital Deal lançou, em novembro, um novo podcast que convida artistas, críticos culturais e profissionais de inteligência artificial a pensar e a debater sobre a relação entre as novas tecnologias e a democracia.

A cidade de Viborg, integrante da Rede de Cidades Criativas da UNESCO para as Media Arts (rede que inclui também a cidade de Braga), está a promover um Programa de Residência ...

O multiplier event “Sharing best practices and results” vai juntar as cidades de Braga, Bucareste (Roménia), Ghent (Bélgica) e Kosice (Eslováquia) numa conferência online, no dia 6 de dezembro, para apresentar os resultados do projeto Youth 4 Bauhaus.

Até 31 de janeiro de 2024, o Europa Criativa - Programa da União Europeia de apoio aos sectores culturais e criativos, promove as open calls “Plataformas Europeias para a Promoção ...

O European Digital Deal, em conjunto com um consórcio de instituições culturais europeias – das quais a Braga Media Arts e o gnration fazem parte – está a promover uma ...

A Gwangju Media Art Platform (G.MAP) e o Governo Metropolitano de Seul juntaram-se para promover uma open call internacional para obras vídeo, aberta a artistas de todo o mundo. Tomando ...

De 9 a 11 de novembro, a Escola das Artes da Universidade Católica Portuguesa apresenta a conferência “Explorations on Sound and New Media Art”. Até setembro, estão abertas inscrições para ...

O Genius Loci Weimar Festival, que decorre no Museu Bauhaus, em Weimar(Alemanha), está a promover uma open call para a elaboração de instalações ou performances que serão apresentadas durante a ...

O grupo artístico CADA e o projeto T-Factor, da Universidade Nova de Lisboa, estão a promover uma open call para uma residência artística destinada a recém-licenciados, artistas emergentes, artistas re-emergentes ...

O Ars Electronica e o Institute of Digital Sciencs da Austria (IDSA) estão a promover uma open call para o programa de educação superior FOUNDING LAB.

Até 23 de junho, a Galeria do Paço da Reitoria da Universidade do Minho receberá a inauguração da segunda edição do eMMA — Exposição do Mestrado em Media Arts da UMinho. ...

Projeto europeu Youth 4 Bauhaus decorreu na passada semana e desafiou jovens portugueses, belgas, romenos e eslovacos a repensar margens do rio Este.

A 13.ª edição do festival Semibreve conta, mais uma vez, com o Prémio Semibreve promovido pela Edigma. Até 15 de julho, estão a ser aceites trabalhos que explorem a interactividade, ...

O projeto está esta semana em Braga com 40 estudantes europeus estão em Braga com o objetivo de encontrar soluções mais inclusivas e sustentáveis para a cidade de Braga, num esforço ...

O Intermediartes - ciclo em Media, Artes e Interação convida académicos, investigadores, artistas e profissionais a submeterem artigos de investigação teórica, prática ou experimental sob forma de short papers, e/ou ...

O Prémio COMEL – Arte Contemporânea está à procura de artistas, com mais de 18 anos, que utilizem alumínio como principal material para trabalhos artísticos de escultura, pintura e fotografia. ...

A cidade criativa da UNESCO das Media Arts recebe a 13.ª edição do festival de música eletrónica e arte digital Semibreve de 26 a 29 de outubro.

O Espaço Alkantara, em Lisboa, está à procura de oito artistas para criação de projetos na área do teatro, dança e performance para fazer parte do Common LAB 2023.

Pelo terceiro ano consecutivo, a Independent Days | Festival Internacional de Cinema de Karlsruhe e a Filmboard Karlsruhe (Alemanha), estão a promover uma open call para realização de um projeto de ...

As candidaturas para os Laboratórios de Verão, programa de apoio à criação artística local, estão abertas até 9 de abril. A iniciativa, promovida pelo gnration e pelo CIAJG - Centro ...

O gnration recebe o artista croata David Sanvicenti para desenvolver novo projeto, no âmbito da European Media Arts Plataform (EMAP). Durante os meses em que estiver em Braga, o artista ...

O Festival Internacional de Vídeo-Dança de Braga está a promover uma open call para trabalhos de vídeo, que serão apresentados em Braga, a 27 de abril, no Theatro Circo. Os filmes devem ser submetidos até 5 de abril.

A Cidade Criativa da UNESCO para as Media Arts acolheu esta semana um encontro da rede europeia EMAP – European Media Art Platform.

Este fim de semana, artistas locais e figuras de referência nacional e internacional voltam a encontrar-se para mais uma edição do OCUPA, que decorre no gnration. Braga, Cidade Criativa da ...

"PoN! - A Ilha dos Tatus" é um jogo para telemóvel ou tablet que pretende envolver jovens em torno da causa climática, da sustentabilidade e da biodiversidade. Partindo da ideia ...

Braga recebe, este sábado, o 2.º Fórum Nacional das Redes UNESCO, no Altice Forum Braga. A edição deste ano tem como tema “O contributo das Redes UNESCO para a construção ...

A cidade de Braga foi selecionada para receber a XVI Conferência Anual da Rede de Cidades Criativas da UNESCO em 2024. A decisão foi anunciada na passada segunda-feira, data que ...

Durante os próximos dias, a cidade criativa da UNESCO para as Media Arts de Braga recebe o festival de música eletrónica e arte digital Semibreve. Até domingo, vários espaços da ...

As cidades criativas da UNESCO para as Media Arts de Braga e Kosice estão a participar no projeto Youth4Bauhaus, destinado a jovens, sobre desenvolvimento urbano sustentável. O projeto, financiado pelo Erasmus ...

As candidaturas para as próximas residências da European Media Art Platform (EMAP) estão abertas. Durante dois meses, entre março e novembro de 2023, os artistas selecionados vão colaborar com um artista ...

De 2 a 4 de setembro, Braga recebe quatro obras, provenientes de outras quatro cidades parceiras europeias e internacionais, inseridas na exposição coletiva “Europe and Beyond”. As peças artísticas de ...

Braga, Cidade Criativa da UNESCO para as Media Arts, é candidata a receber em 2024 a conferência anual que junta vários representantes da Rede de Cidades Criativas da UNESCO. Na ...

A Cidade Criativa da UNESCO para as Media Arts de Košice, na Eslováquia, vai receber uma residência artística de dois meses para artistas e cientistas. Esta Open Call oferece uma ...

O projeto Cartografias Imaginárias, inserido na programação do Circuito - Serviço Educativo Braga Media Arts, e que juntou estudantes das cidades criativas para as Media Arts de Braga e Enghien-les-Bains, ...

Em parceria com a Nu Boyana Portugal, o serviço educativo da Braga Media Arts apresenta o BMA lab: fazer filmes - como passar do papel à tela, este sábado, no gnration. ...

Em outubro, a cidade criativa da UNESCO para as Media Arts de Braga volta a dar palco ao festival de música eletrónica e arte digital Semibreve. Alva Noto, Gábor Lázar, ...

Inaugura hoje, 24 de maio, a exposição eMMA - Exposição do Mestrado em Media Arts da UMinho na Galeria do Paço. Esta exposição conta com oito projetos artísticos de grupos de ...

A primeira edição da bienal de arte e tecnologia Index, promovida pela Braga Media Arts, começou esta quinta-feira, com o espetáculo de Ryoichi Kurokawa. O artista japônes subiu ao palco ...

A performance de vídeo-dança Blossom/Florescer e a instalação de Rui Sebastian são alguns dos destaques da programação do festival Política, que acontece de 5 a 7 de maio, em Braga. ...

De 31 de maio a 3 de junho, realiza-se uma Learning, Teaching Training Activity (LTTA), inserida no projeto FAIaS – Fostering Artificial Intelligence at Schools. Esta formação pretende melhorar a compreensão das ...

Estão abertas as candidaturas para a edição de 2022 dos Laboratórios de Verão. A iniciativa, promovida pelo gnration, oferece apoio financeiro e logístico para a criação de conteúdos artísticos originais. ...

Braga e Enghien-les-Bains (França), cidades criativas da UNESCO para as Media Arts, estão a colaborar no projeto Cartografias Imaginárias, promovido pelo Circuito - Serviço Educativo Braga Media Arts. Entre 19 e 21 ...

A Fundação Calouste Gulbenkian e a Escola das Artes da Universidade Católica do Porto estão a promover um Curso de Formação Avançada em Realização em Cinema e Televisão, que decorrerá ...

A 12.ª edição do festival Semibreve conta, mais uma vez, com o Prémio Semibreve promovido pela Edigma. Até 15 de julho, estão a ser aceites trabalhos que explorem a relação ...

A European Media Art Platform (EMAP) está a promover uma open call para um programa de residências artísticas na área da arte digital, media art e bio-art. A open call, ...

A mais antiga aliança diplomática vai ser comemorada com um vasto conjunto de iniciativas a decorrer na cidade de Braga. Neste âmbito, e no contexto de Braga enquanto Cidade Criativa ...

A instalação LIMBO, de João Carlos Pinto, está em exposição no Listasafn Reykjanesbærjar – Reykjanes Art Museum, na Islândia. O trabalho do artista bracarense poderá ser visitado até 24 de abril ...

Artistas ucranianas refugiadas podem, a partir de hoje, candidatar-se a uma das seis bolsas de residências artísticas promovidas pelo dstgroup e pela Zet Gallery.

Amanhã, 24 de fevereiro, decorre uma Mesa Redonda sob o tema “Desafios da ética e da governação da IA: dos princípios à prática”, em formato online. Este webinar pretende identificar ...

O MArteLive 2022 está à procura de artistas europeus em 16 áreas criativas. Dança, música, teatro, ilustração digital, fotografia, escultura e design de moda são algumas das vertentes que fazem ...

Medialab Matadero vai promover laboratórios interdisciplinares de investigação e produção colaborativa. Até 27 de fevereiro está a decorrer uma open call para o workshop intensivo “Laboratório de Prototipagem Colaborativa”, primeiro ...

Esta quarta-feira, 9 de fevereiro, Braga estará novamente no centro das atenções da relação da arte com a tecnologia. A partir do salão nobre do Theatro Circo, vão ser dadas ...

A galeria Forum Arte Braga recebe a obra When I Think of you I Shiver in Awe do artista grego Manolis D. Lemos, em fevereiro. A obra poderá ser visitada de 17 de fevereiro a 11 de março.

O projecto Audire tem candidaturas abertas para a apresentação de artigos o e obras artísticas para a Conferência "Experiências Sonoras". A conferência realiza-se em Braga, de 27 a 28 de Junho.

Em colaboração com INDEPENDENT DAYS | Internationale Filmfestspiele Karlsruhe, a Filmboard Karlsruhe está a oferecer uma bolsa de 3.000 euros para realização de um projeto para cineastas independentes.

Os prémios The Sound of the Year estão de volta para mais uma edição com mais de 16 categorias a concurso. A iniciativa organizada pelo The Museum of Sound, The ...

Braga e a cidade francesa Enghien-les-Bains integram o programa oficial da Temporada Portugal - França 2022, que decorre de fevereiro a outubro de 2022. Ao longo dos próximos meses, as ...

O Festival Little Islands (LIF) liga a paisagem e a natureza do mar Egeu com artes visuais. Esta open call destina-se a todas as comunidades artísticas que explorem práticas artísticas ...

A música eletrónica e a arte digital voltam a estar em foco no OCUPA. Ao longo de três dias, o gnration vai ser palco de performances, conversas e exposições. A sexta edição ...

O Mosteiro de Tibães vai dar palco ao projeto Sons de Bolso, que juntou seis compositores portugueses para criar obras originais sobre espaços importantes do património cultural português. A 18 ...

As candidaturas para propostas artísticas para a edição de 2022 desta Bienal de Arte e Tecnologia podem ser enviadas até 15 de dezembro. Esta open call tem como objetivo selecionar ...

O projeto City to City foi distinguido com o prémio “Best Internacional Project” da fundação italiana Santagata. Criado em 2020 pela Rede de Cidades Criativas da UNESCO para as Media ...

Hamar (Noruega), Modena (Itália), Campina Grande (Brasil), Namur (Bélgica) e Tbilisi (Geórgia) são as novas cinco cidades criativas da UNESCO para as Media Arts.

A inauguração da exposição coletiva "In bed with a mosquito", acontece este sábado, na Galeria Duarte Sequeira. A inauguração acontece às 18:00 e a entrada é livre.

A edição de 2022 do Index decorrerá entre 12 e 22 de maio e explorará o conceito de Superfície. O Index é uma Bienal de Arte e Tecnologia, inserida no programa da cidade de Braga como Cidade Criativa da UNESCO para as Media Arts.

Esta open call tem como objetivo selecionar e apoiar propostas artísticas na interseção entre a Arte e a Tecnologia com estreita ligação ao tema da Bienal de 2022, que integrarão o seu programa online.

O artista multidisciplinar bracarense, Miguel De, apresenta a performance-concerto "PNRM". O espetáculo acontece a 24 de outubro, no Centro da Juventude de Braga.

A instalação LIMBO, do artista bracarense João Carlos Pinto, está em exposição no evento no Connected Future – The Media Art Festival Seasons of Media Arts, em Karlsruche, até 17 de ...

O Prémio “Minho Storytelling – Novos Olhares sobre o Minho”, o Consórcio Minho Inovação - liderado pelas Comunidades Intermunicipais do Alto Minho, do Ave e do Cávado - promove agora ...

AcustiCidade, projeto sonoro documental do Circuito, serviço educativo da Braga Media Arts, procura contar a história das urbanizações bracarenses através de testemunhos dos seus moradores e da captação de paisagens ...

Košice, cidade criativa das Media Arts, convida artistas para uma residência artística de dois meses durante este outono.

Jorge Pinto Ramos é o artista bracarense escolhido para representar Braga na edição deste ano do City to City, iniciativa que incentiva à criação de novas peças de arte através ...

Este Verão, o Art Center Nabi vai acolher o evento Nabi Online Hackathon <Hello, World!: new playground>, sob o tema Inteligência Artificial, de 12 a 14 de agosto. O Art Center Nabi está ...

Com o apoio da Braga Media Arts, Universidade do Minho lança mestrado em Media Arts e reforça centralidade da universidade no plano cultural e criativo da cidade de Braga.

A Conferência Internacional de Transições de Sustentabilidade (IST) acontece de 5 a 8 de outubro de 2021, organizada pelo Instituto Fraunhofer para Pesquisa de Sistemas e Inovação (ISI), numa cidade das ...

A 10.ª edição da Conferência Internacional da EAI ArtsIT acontece em Karlsruhe, cidade das Media Arts, sob o tema "Inovação, Virtualização e Inteligência Artificial". De 02 a 04 de dezembro ...

A Braga Media Arts está à procura de um artista, residente ou natural no concelho de Braga, para a realização de um projeto de colaboração artística com artistas de outras ...

É responsável ou colaborador numa instituição da cidade de Braga? Perto é um ciclo de sessões de exploração sonora para comunidades institucionalizadas, proporcionando uma vivência artística ativa e seguramente benéfica ...

O gnration está a promover edição dos Laboratórios de Verão de 2021. A iniciativa, que oferece apoio financeiro e logístico para a criação de conteúdos artísticos originais, tem candidaturas abertas até 16 de ...

A IMPROVISA.Life in Motion convida os artistas da UE a apresentar propostas com novas abordagens para envolver novos públicos em conteúdos culturais e patrimoniais através do princípios de improvisação e ...

Face às atuais necessidades do setor cultural, a Fundação Gulbenkian apoia a criação artística individual e coletiva de obras originais nas áreas das artes visuais, cinema, dança e teatro.

A 7.ª edição do ArtCamp Andorra - "Cores do Planeta" pretende promover a diversidade cultural, o diálogo da paz entre artistas e o desenvolvimento sustentável. O encontro de pintores acontece de 14 a 25 de julho, em Ordino (Andorra).

Junto com o INDEPENDENT DAYS | Internationale Filmfestspiele Karlsruhe, o Filmboard Karlsruhe oferece a cineastas independentes a possibilidade de produzir uma curta-metragem com orçamento no valor de 3.000 euros. A iniciativa ...

O i-Portunus é um projecto, seleccionado e financiado pela União Europeia, para testar um esquema de mobilidade para artistas e profissionais da cultura.

Oportunidade para Residências Artísticas totalmente financiada (viagens, alojamento, um estipêndio e custos de produção).

Pode um desenho mudar o mundo? A convite da cidade Viborg (Dinamarca), também Cidade Criativa da UNESCO para as Media Arts, a Braga Media Arts associou-se ao projeto "DANMARKS INDSAMLING ...

A SonaeSierra e o NOVA ARCADA, através da CREATIVE INDUSTRIES PROGRAMMES by SC, no âmbito da sua actividade regular de envolvimento com a Comunidade, pretende desafiar as associações, coletivos e companhias ...
A todos os cientistas, artistas, instituições, laboratórios e empresas: começa hoje a chamada à submissão de projetos para o Prémio STARTS 2021 da Comissão Europeia. Os trabalhos propostos devem ser ...

Em 2021, o Circuito convida todos os músicos amadores, residentes ou naturais de Braga, interessados em participar da criação de música a partir de dispositivos eletrónicos, a fazer parte desta ...

Em 2020, procurando dar resposta a um tempo extraordinário com particulares desafios colocados ao meio artístico e cultural, nove Cidades Criativas da UNESCO em Media Arts: Austin (Estados Unidos), Braga ...

Dirigida a todos os artistas interessados em realizar projetos em diálogo com físicos e engenheiros e num contexto de laboratório. Collide é uma residência de dois meses totalmente financiada que ...

Joana Miranda, Coordenadora Executiva da Braga Media Arts, é uma das oradoras convidadas da conferência ICT Meets the ARTS, organizada pela Porto Design Factory, no contexto do projecto RegionArts, apoiado pelo programa Interreg Europe.

O músico João Carlos Pinto foi o vencedor da cidade de Braga da open call da iniciativa "City to City: Human Responsibility", que junta num só propósito diferentes Cidades Criativas da UNESCO para as Media Arts.

O Prémio IN3+ da INCM (Imprensa Nacional Casa da Moeda), um dos maiores prémios de apoio à inovação, investigação e desenvolvimento nacionais, já tem nova data de fecho para entrega ...

As Cidades Criativas da UNESCO Portuguesas estiveram ontem reunidas em Leiria para um encontro de consolidação e definição de atividades a desenvolver no futuro, em parceria.

Amanhã o Festival Ars Electronica inicia uma viagem por Amesterdão, Bruxelas e Braga.

Inserido na programação do Ars Electronica, o gnration apresenta uma tour virtual da exposição "The Invention of Sense", de Marcel Weber.

As Cidades de Austin (EUA), Braga (Portugal), Calí (Colômbia), Changsha (China), Guadalajara (México), Karlsruhe (Alemanha), Kosice (Eslováquia), Sapporo (Japão), Viborg (Dinamarca) and York (Reino Unido), membros do Cluster de Cidades Criativas ...

A Braga Media Arts estará hoje presente na Covilhã num evento dedicado às Cidades Criativas da UNESCO portuguesas. Juntamente com os representantes das cidades de Amarante, Barcelos, Idanha-a-Nova, Leira e Óbidos, a ...

No contexto da estratégia Braga Cultura 2030 e da candidatura de Braga a Capital Europeia da Cultura 2027, o Município de Braga encomendou ao Observatório de Políticas de Comunicação e Cultura ...

O ILFU - Festival Internacional de Literatura de Utrecht está a lançar um concurso internacional de histórias. Sob o tema "Rising", qualquer pessoa com mais de 16 anos pode candidatar-se, ...

Foi na passada sexta-feira que o Theatro Circo apresentou, em conferência de imprensa, os resultados relativos ao ano de 2019, bem como uma análise de toda a atividade criada durante o período de confinamento e pós-confinamento.

As medidas de contenção e as restrições de mobilidade adotadas por muitos países para conter a pandemia restringiram drasticamente o acesso à cultura, tornando o ecossistema cultural mais frágil, principalmente ...

A Trans Europe Halles está à procura de iniciativas cívicas emergentes com foco nas artes, na cultura e na criatividade, localizadas em edifícios reutilizados para participarem na 4ª edição do seu programa ...

A galeria Pitroda Art está a promover um conjunto de ações que pretendem colocar a arte como motor para a transformação social. MOVEMENT é o nome de um conjunto de atividades ...

A Digital Earth está a receber candidaturas para a "Digital Earth Fellowship" 2020-2021. Destinada a 8 artistas e/ou duplas de diferentes áreas, esta bolsa de 9 meses inicia em setembro ...

O projeto Audire, do Centro de Estudos de Comunicação e Sociedade (CECS) da Universidade do Minho, vai promover no próximo dia 17 de julho, às 11h, uma mesa redonda sobre o ...

O Circuito está a promover, até 22 de julho, uma open call dirigida a todos os residentes de Braga, os que sempre aqui viveram e os que escolheram a cidade para viver, para participarem no espetáculo colaborativo “Igual diz-se de muitas maneiras”.

O Circuito – Serviço Educativo Braga Media Arts continua à procura de instrumentistas para a ODE, a sua Orquestra de Dispositivos Eletrónicos. Se tens entre 15 e 18 anos e ...

A Braga Cultura 2030, a estratégia cultural que está a preparar a candidatura de Braga a Capital Europeia da Cultura 2027, preparou um questionário dirigido a todos os artistas, agentes culturais ...

A décima edição do Festival Semibreve conta mais uma vez com o Prémio Semibreve patrocinado pela Edigma, uma empresa portuguesa líder no desenvolvimento de experiências interativas, tecnologia multi-touch e projetos digitais.

A cidade de Košice está a lançar uma chamada pública a artistas que sejam naturais, residentes ou que trabalhem nas Cidades Criativas da UNESCO, para fazerem uma residência artística de dois ...

Hoje, a partir das 18h30, pode rever a Mesa Redonda "O erro no contexto de processos tecnológicos e criativos", que teve lugar no gnration no dia 29 de fevereiro, no contexto do "Construção de um index #1".

A Galeria Duarte Sequeira, sediada em Tibães, Braga, vai participar na edição online da ARCOlisboa 2020, numa parceria com a Artsy, com a representação dos artistas Jonathan Uliel Saldanha, Petros Moris, Vanessa da Silva e Mimosa Echard.

Hoje, a partir das 18h30, pode rever a Mesa Redonda "Arte, tecnologia e ciência: novos caminhos para uma longa relação", que teve lugar no gnration no dia 29 de fevereiro, no contexto do "Construção de um index #1".

O workshop "O sampling como ferramenta de composição musical", orientado pelo músico David Bruno está online e disponível até ao próximo dia 31 de maio.

Encontrar soluções tecnológicas que promovam a literacia em adultos ao longo da vida foi o mote para a criação do Gulbenkian Award for Adult Literacy, promovido pela fundação em parceria com o Solve – MIT.

Até 13 de maio de 2020 pode apresentar candidaturas à 1ª edição da revista Marvelous Art Magazine, da Marvelous Art Gallery.

A pandemia do covid-19 obrigou muitas empresas a mudar rotinas, particularmente empresas que dependem do funcionamento de outras. Vejamos o caso da Your Podcast, parceira da Braga Media Arts.

Decorrem até 30 de junho as candidaturas à open call "Portuguese Emerging Art 2020".

Se quer ter acesso a arte e cultura sem sair de casa saiba que o Museu dos Biscainhos, em Braga, está a fazer visitas virtuais guiadas.

Muitas portas se fecharam neste início de 2020. Surgiram as incertezas, a letargia, a aflição, mas também instituições e pessoas que não quiseram baixar os braços. A zet gallery é um desses exemplos.

Já abriu o concurso para a primeira edição da PARTIS & Art for Change.

Na senda do trabalho de comunidade que tem desenvolvido, a Cosmic Burger lançou uma campanha online para angariar fundos para apoiar artistas, impedidos pela atual conjuntura de desenvolver a normal atividade.

Termina a 30 de abril o prazo de candidaturas às Bolsas Jovens Criadores 2020.

Chama-se “Somos Tod@s Digitais” e quer pôr a mexer quem tem de ficar em casa. Porque comunicamos cada vez mais à distância, fruto da nova realidade que enfrentamos, as competências digitais são fundamentais para quebrar o isolamento social.

Guadalajara, cidade criativa da UNESCO, em parceria com o British Council e o Conselho Promotor de Inovação e Design estão a preparar uma espécie de sprint criativo online, um espaço de diálogo que permita a troca de ideias.

O gnration promove este ano a quinta edição dos Laboratórios de Verão. Destinada a artistas ou coletividades do distrito de Braga que produzam conteúdos artísticos originais, a iniciativa arranca a 3 ...

A “Doing Business”, evento da ScaleUp Porto que chega à sua 5ª edição, este ano será realizada em parceria com a UPTEC - Parque de Ciência e Tecnologia da Universidade do Porto.

O diretor artístico e coordenador de programação da Braga Media Arts Luis Fernandes, a dupla de designers FalcãoLucas e o artista e diretor de arte João Pombeiro vão estar hoje ...

Estará connosco nos moldes convencionais quando o tempo assim o permitir. Enquanto estamos ainda em auto-confinamento, Angélica Salvi dá hoje um pequeno concerto inserido na programação online do 105º aniversário do Theatro Circo.

É já amanhã que o Theatro Circo comemora 105 anos de existência. Um aniversário que este ano, devido a circunstâncias inesperadas, é comemorado de forma virtual.

Como podem as indústrias culturais e criativas ajudar a enfrentar melhor os novos desafios com os quais nos confrontamos? E como podem os governos nacionais e locais aliviar os efeitos a curto e longo prazo desta crise nas indústrias criativas?

Depois de ter lançado a campanha #ShareOurHeritage, a UNESCO comemora esta quarta-feira o Dia Mundial das Artes e lança um outro movimento global. Chama-se ResiliArt e consiste numa série de debates virtuais e iniciativas nas redes sociais.

Em virtude das recomendações da Direção-Geral da Saúde (DGS) e tendo em conta a implementação do Plano Nacional de Preparação e Resposta à Doença por novo Coronavírus (COVID-19), e em ...

O trinómio arte, tecnologia e ciência foi o ponto de partida para Construção de um index #1, iniciativa que decorreu no passado fim-de-semana no gnration e que trouxe a Braga, artistas, professores, curadores, cientistas e cineastas.

Depois de em 2019 ter testemunhado o nascimento do index, o primeiro evento internacional focado na relação entre arte e tecnologia, este ano Braga vai receber um conjunto de sessões intituladas construção ...

A Fundação Calouste Gulbenkian abriu candidaturas para bolsas que se destinam a apoiar projetos na área das artes visuais, curadoria, cinema, teatro e dança.

Los Angeles, na Califórnia,recebe a Technarte | Conferência Internacional de Arte e Tecnologia, nos dias 6 e 7 de agosto de 2020

A OSSO Colectivo lançou um programa de residência artística e convida artistas e investigadores de todas as áreas a submeter a sua inscrição.

Por razões de ordem familiar, o workshop “A Closer Listen”, de Jana Winderen, agendado previamente para 25 de janeiro e adiado recentemente a pedido da artista, não terá data de reposição próxima, sendo assim cancelado.

A Edith-Russ-Haus for Media Art abriu candidaturas para a atribuição de três bolsas de criação para media arts da Foundation of Lower Saxony.

As candidaturas ao prémio internacional de arte digital Lumen Prize, organizado anualmente pela Lumen Art Projects, vão decorrer de 15 de fevereiro a 5 de maio de 2020.

Já se encontram disponíveis as inscrições para a 1ª Edição dos Cursos Avançados, organizada pelo Laboratório de Inteligência Artificial Aplicada (2Ai), da Escola de Tecnologia (EST), do Instituto Politécnico de ...

A Imaginando, startup de tecnologia que cria ferramentas e instrumentos para a indústria da música, está a desenvolver uma plataforma com uma empresa norte-americana, uma espécie de Skype para Pro Audio.

Grande prémio da Comissão Europeia dedicado à inovação em tecnologia, indústria e sociedade em estreita sinergia com as artes.

Em 2019 Braga viu nascer o index, o primeiro evento internacional focado na relação entre arte e tecnologia, criado desde a atribuição à cidade do título de cidade criativa da unesco ...

A Comissão Diretiva da Austin City of Media Arts da UNESCO, em parceria com a Divisão de Artes Culturais do Departamento de Desenvolvimento Económico está a receber inscrições para Mostra ...

O Circuito – Serviço Educativo Braga Media Arts está a receber inscrições para o espetáculo de comunidade Igual diz-se de muitas maneiras. O desafio é lançado a todos os novos ou ...

O Circuito - Serviço Educativo Braga Media Arts está a receber inscrições para a ODE: Orquestra de Dispositivos Eletrónicos. Se tens entre 15 e 18 anos, inscreve-te gratuitamente!

O Circuito - Serviço Educativo Braga Media Arts tem o seu arranque simbólico na Noite Branca Braga 2019, com o espetáculo Circuito. Dia 6 de setembro, às 21h30, no Palco Praça.

O Teatro Circo, EM, S.A., entidade responsável pela implementação do plano de ação de Braga Media Arts, Cidade Criativa da UNESCO, no âmbito do CIRCUITO (serviço educativo de Braga Media ...

O index - da arte e tecnologia, foi oficialmente apresentado ontem, num evento de lançamento que teve lugar no gnration.

Ensaio Aberto da Oficina "Calígula Morreu. Eu não." no dia 6 de julho, às 16h00, no gnration.

O INL lançou novo programa de mobilidade no âmbito do projeto nanoGateway.

Agora pode saber tudo o que se passa em Braga na área das Media Arts através da nossa newsletter.

O Serviço Educativo Braga Media Arts e a Terra Amarela estão em busca de 5 pessoas para integrarem o grupo de trabalho da Oficina Criativa Inclusiva Calígula Morreu. Eu não.

O media artist João Martinho Moura mantém duas exposições na Coreia do Sul. How Computers Imagine Humans? no contexto do ISEA 2019, em Gwangju, e Sci-fi Miners, no Art Center Nabi em Seoul.

O Instant Ensemble interpreta o filme clássico e de raras apresentações públicas, "a dança dos paroxismos" (1929), de Jorge Brum do Canto, num espetáculo audiovisual para toda a família.

Esta terceira fase do RoadShow Escolar leva-nos à Escola Secundária de Maximinos para uma intervenção pedagógica dos alunos de Design de Produto da Universidade do Minho, focado em grupos de alunos cegos e com baixa visão.

“ARTECH 2019 - Digital Media Art Ecosystems” é uma conferência Internacional sobre Artes Digitais e Interativas, organizada pelo Theatro Circo, pelo Centro Regional de Braga da Universidade Católica Portuguesa e ...

A Experience Changsha Media Arts Residency fez parte do Festival de Media Arts de Changsha e do Fórum Internacional da Juventude sobre Criatividade e Património ao longo da Rota da ...

O ciclo Binário apresenta algumas das mais entusiasmantes performances audiovisuais a que é possível assistir. No dia 8 de Maio, os artistas canadianos Alexis Langevin-Tétrault, Guillaume Côté e Dave Gagnon, sobem ao ...

O festival Semibreve regressa a Braga mais uma vez para celebrar a música eletrónica a as artes digitais, anunciando novamente o prémio Semibreve, aberto a trabalhos na área do audiovisual, tecnologia e interatividade.

A cidade de Braga volta a vestir-se de branco em 2019, com diversas atividades desde animação de rua a performances, instalação ou dança. Para complementar este programa, a Fundação Bracara lança um ...

O RoadShow escolar regressa na última semana de Abril para mais uma mostra de trabalhos, desta feita com seis curtas preparadas pela Escola e Design do IPCA, em duas escolas da cidade.

A 27 de abril, o sexto aniversário do gnration será celebrado com um conjunto de atividades gratuitas que se unem por uma curiosa e nova abordagem à eletrónica e à tecnologia.

O Serviço Educativo da Braga Media Arts convida cantores ou coros a participar no projeto "espetáculo de comunidade", integrado na Noite Branca Braga 2019.

O festival de fotografia e artes visuais de Braga, Encontros de Imagem, regressa em 2019 para mais uma edição espalhada pela cidade, associada a uma call for artists.

A Bienal de Artes Contemporâneas BoCA, regressa este ano com passagem garantida por Braga. Várias instalações, performances e exposições serão exibidas em vários espaços da cidade, entre 15 de março e 30 de abril.

O Mini Mapa Sonoro é a mais recente atividade do Serviço Educativo Braga Media Arts, proposta para o ano letivo 2018/2019. Um conjunto de mapas audiovisuais e interativos que descrevem as escolas pelos seus alunos.

A Medea Electronique abriu candidaturas para a sua residência artística no sul da Grécia até ao dia 1 de Abril. A Koumaria 2019 tem como tema "Improvising the Archive/Archiving the Improvisatory" e ...

O Eyebeam Center for the Future of Journalism (ECFJ) é um programa experimental para concessão de fundos a jornalistas que produzam trabalhos inovadores para grandes meios de comunicação. Estão neste momento ...

Depois do sucesso em toda a linha que foi o RoadShow de 2018, seis grupos do Mestrado em Multimedia da Universidade do porto regressam a Braga para uma série de instalações nas Escolas Secundárias Sá de Miranda e Carlos Amarante.

A New Technology Art Award seleciona e apresenta criações nas quais a formação tecnológica aplicada à arte desempenha um papel central. Promovem uma call até 31 de Março para trabalhos na ...

A Artemrede, através do projeto RESHAPE, do qual é parceira, lançou uma convocatória para artistas e agentes culturais com a vista a criar grupos de trabalho para a inovação no ...

Decorre até 23 de Janeiro o prazo para candidaturas à edição 2019 do Programa de Desenvolvimento de Artistas promovido pelo Banco Europeu de Investimento (Instituto BEI), que visa selecionar um ...

O Vector Festival está solicitando candidaturas de obras de arte para o seu programa de 2019, que incluirá uma exposição no InterAccess durante julho e agosto, em várias categorias dentro das ...

Conheça o Programa de Residências de Media Arts da cidade chinesa de Changsha, parte do Festival de Media Arts de Changsha e do Fórum Internacional da Juventude sobre Criatividade e Património ao longo da Rota da Seda.

Estão abertas as candidaturas para nova edição do Santa Casa Challenge, promovido pela Casa do Impacto, o novo polo dedicado ao empreendedorismo e inovação social da Santa Casa da Misericórdia de Lisboa.

A Ci.CLO Bienal Fotografia do Porto abriu candidaturas para atribuição de duas bolsas de criação, na área da fotografia e/ou vídeo, para desenvolvimento de novos projetos com exposição integrada na Bienal´19.

A Sociedade artística francesa Adami e o pólo de artes digitais Centre des arts d'Enghien da nossa cidade homóloga francesa, associam-se para lançar uma candidatura aberta, dirigida a uma equipa de artistas na área das artes performativas.

O Município de Braga apresentou no passado dia 7 de Dezembro, na Fundição de Sinos de Braga, o processo de desenvolvimento de uma Estratégia Cultural, denominada ´Braga Cultura 2030´, para o horizonte temporal de 2020-2030.

O Ashurst Emerging Artist Prize está aberto a inscrições de artistas em qualquer parte do mundo. As candidaturas podem ser submetidas sob qualquer media, numa variedade de formatos, incluindo pintura, fotografia ou nem media.

No próximo ano civil, surge um novo ciclo de workshops na área das media arts com o selo BMA. O BMA lab reúne três iniciativas de Janeiro a Março com ...

Pelo terceiro ano consecutivo, a mostra de arte digital e música eletrónica, Ocupa, regressa ao gnration com uma mão cheia de conversas e performances na perspectiva de uma produção artística em ambos os domínios.

Futuramente tudo aquilo que imagines pode se tornar realidade, por isso as opções são infinitas… O Athens Digital Arts Festival está a lançar um concurso público para a sua 15ª edição ...

Este conjunto de Ações de Curta Duração, preparadas pelo serviço educativo Braga Media Arts ocupa o espaço entre a criação, as Media Arts e a comunidade. Serve para que os docentes ...

Decorre até 15 de novembro de 2018 o prazo para submissão de candidaturas à 18.ª Media Art Biennale WRO 2019 Human Aspect. A WRO Media Art Biennale é o principal fórum de ...

Estão abertas as candidaturas para a 13ª edição Prémio Novos Artistas Fundação EDP. Esta é uma iniciativa bienal que visa revelar e apoiar o talento nacional emergente no domínio das artes plásticas e visuais.

A nova European Media Art Platform oferece residências para media artists nos campos da media digital, incluindo artistas baseados na Internet e em informática, cineastas e aqueles que trabalham em performance, som ...

De 13 de setembro a 21 de outubro, o Sapporo Tenjinyama Art Studio em parceria com a cidade criativa de Sapporo, convida artistas da área das media arts para uma open call do seu programa de residências de inverno.

A cidade criativa de Austin convida artistas das várias cidades homólogas da UNESCO a concorrer ao seu concurso público com projectos digitais para o Festival South by Southwest (SXSW) 2019.

Temp Studio é um local de encontro e intercâmbio de experiências para novos media artists. Um programa de residências de uma semana que acontece duas vezes por ano, oferecendo um espaço ...

O Centro de Estudos de Comunicação e Sociedade da Universidade do Minho e as cinco cidades portuguesas da Rede de Cidades Criativas da UNESCO vão organizar as próximas 2CN-CLab TALKS ...

Duas bolsas de investigação no campo da electrónica e da informática estão disponíveis para o projeto MoBeyBOU: Moving Beyond Boundaries - Projetando a aprendizagem narrativa na era digital.

A iniciativa, lançada pela Portugal Ventures, possibilita o acesso a investimento de projetos inovadores na área da tecnologia, digital, robótica e que prevejam a sua valorização e comercialização no mercado global.

Foi apresentado ontem, dia 16 de Julho, o Projecto Preliminar desenvolvido para a requalificação e ampliação do antigo cinema São Geraldo no sentido de obter contributos da sociedade civil para a definição final a implementar.

Temos o prazer de informar que a convocatória para inscrições de participação no 4º workshop internacional da Academia sobre Designações da UNESCO e Desenvolvimento Sustentável, está neste momento aberta. O workshop será realizado ...

A EB1 de Frossos foi uma das nove escolas que, no presente ano lectivo, usufruiu dos workshops do programa 0+1=Som, inserido na agenda da Braga Media Arts.

Creative Industry Košice, o ponto de contacto da cidade criativa das medias arts eslovaca, está a convocar uma OPEN CALL para palestrantes na Conferência de Arte e Tecnologia agendada para Novembro deste ano.

Impulsione seus negócios com a integração de soluções baseadas em nanotecnologia. O INL ajuda-o a suster o seu negócio e a dar-lhe acesso a um ecossistema que o ajudará a ...

Temos o maior prazer em anunciar que os nossos colegas de York Mediale, a Cidade Criativa das Media Arts da UNESCO e a equipa de Economia Criativa do British Council está a lançar um convite ...

2018 marca o décimo aniversário do projeto Fanzine e, para isso, a organização deu um passo em frente, criando uma experiência multidisciplinar para um público mais extenso. Está aberta então ...

Uma nova edição do prémio Semibreve terá lugar em 2018 com o apoio especial da Edigma, empresa Portuguesa líder no desenvolvimento de experiências interativas, tecnologia multi-toque e projetos de digital signage.

Até ao dia 10 de julho decorre a 1.ª fase do período para apresentação de candidatura aos mestrados da Escola Superior de Tecnologia do IPCA.

A Braga Media Arts promove mais um concurso público da Associação Cultural de Fotografia e Artes Visuais, Encontros da Imagem, desta feita sob o tema “O Belo e a Consolação” para o Festival Discover Awards 2018.

A cidade de Braga volta a vestir-se de branco em 2018. Para a edição deste ano, a Noite Branca Braga ança um concurso aberto a toda a comunidade na procura de atividades culturais integradas no próprio evento.

O Programa Fuel garante aos empreendedores a energia, as condições e a rede de contactos necessárias para fazer grandes ideias florescer.

O Teatro Gil Vicente de Barcelos, recebe a segunda edição da DIGICOM, uma conferência internacional de Design e Comunicação Digital, organizada pela Escola Superior de Design do Instituto Politécnico do Cávado e do Ave.

Após duas edições de sucesso, o gnration volta a apresentar Laboratórios de Verão, uma iniciativa destinada a artistas ou coletividades de Braga, que se proponham a desenvolver conteúdos artísticos originais para ...

Os alunos das Escolas Básicas da Estrada, do Agrupamento de Maximinos, e de Merelim S. Paio, do Agrupamento Mosteiro e Cávado, subiram no passado sábado ao palco do gnration para mostrar o trabalho desenvolvido no âmbito do projecto 0+1=SOM.

A Designregio Kortrijk está à procura de 3 criadores de design altamente motivados e recém-formados ou artistas criativos para se juntarem a uma residência regional em Kortrijk, na Bélgica.

Na passada semana, durante o dia 12 de Abril, o programa 0+1=Som regressou a Braga, com o objetivo de preparar uma sessão de carácter performativo a apresentar no gnration open day.

O Festival EVA vai este ano para a sua 7ª edição. É um evento criado por alunos e docentes do curso de Design Gráfico e Multimédia todos os anos. O ...

No âmbito do ‘B de Dança’, o Município de Braga lança este ano um novo desafio a todos os apaixonados pela arte da dança e fotografia com a realização do ‘I Photo Dance Walk Braga’.

O Douro vai premiar os seus criativos! Inscreve-te e mostra ao mundo as tuas ideias e projetos! O Prémio Douro Criativo exalta os criativos da região e de todo o ...

Em 2018, o Programa de Estágios de Verão do INL realizará sua 5ª edição e selecionará 25 alunos com um distinto desempenho académico para fazer parte desta experiência de Verão. ...

No âmbito do Prémio de Inovação CÓDIGOMÁIS, nove projetos inovadores na área de Saúde e Envelhecimento foram selecionados pela sua valorização e transferência para o mercado, entre eles o BIO2SKIN do ...

O concurso NORTE MULTIMÉDIA surge no âmbito dos Prémios “O Norte somos nós” e pretende contribuir para a revelação de novos fotógrafos, realizadores e produtores, profissionais e amadores, expondo o ...

Depois de uma primeira edição bem sucedida, o Temp Studio #2 acontecerá novamente em Lisboa entre 13 a 19 de maio de 2018. Você pode inscrever-se com uma proposta inovadora ...

O Festival SXSW em Austin, Estados Unidos, tem sido um viveiro para as indústrias criativas, digital media e tecnologia. O evento reúne várias comunidades de cinema, música e jogos digitais ...

A Semana de Design de Shenzhen deste ano incluirá uma Exposição Especial da Unesco Creative Cities Network intitulada "As Possibilidades de Design: Perspectivas UCCN". Shenzhen convida todas as cidades criativas da UNESCO a propor projetos inovadores.

O RoadShow Escolar de 2018 fez o seu périplo pelas escolas de Braga com seis exposições interativas organizadas e projetadas pelos alunos do Mestrado em Multimédia da Universidade do Porto.

A agência de publicidade Hakuhodo e a Ars Electronica convidam-no a participar de um brainstorming coletivo acolhido na mega-cidade japonesa! A Cimeira dos Futuros Inovadores em Tóquio procura participantes interessados ...

VERTIGO é um projeto apoiado pelo programa H2020 STARTS da Comissão Européia. O objetivo é organizar colaborações artísticas com projetos de I&D que visem a inovação.